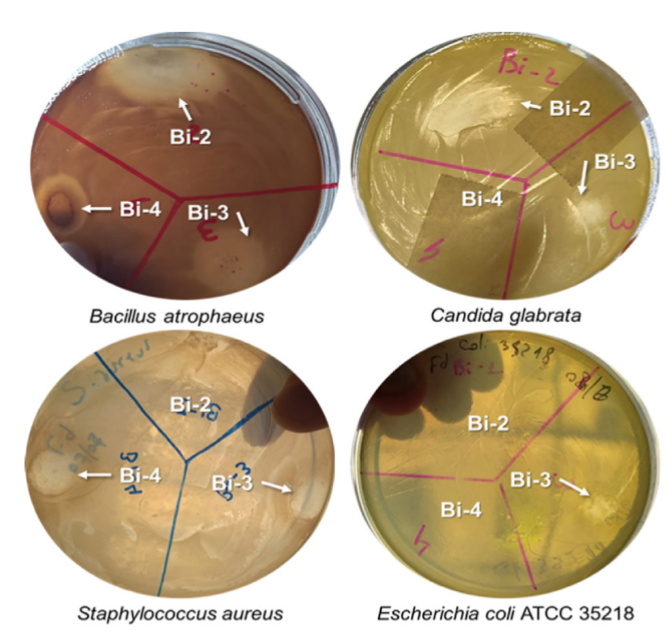

- Noticias / Química: Revista internacional selecciona ilustración de investigadores de San Luis
PUBLICACIÓN CIENTÍFICA
Química: Revista internacional selecciona ilustración de investigadores de San Luis
La ilustración autoría de Federico Aballay y Germán Gomez fue elegida como portada de la prestigiosa revista internacional EurJIC (European Journal of Inorganic Chemistry), especializada en Química Inorgánica.
Compartir en
redes sociales
Por Daniel Toledo - Área Comunicación Institucional INTEQUI (©)
La revista científica internacional EurJIC (European Journal of Inorganic Chemistry) especializada en química inorgánica, en su edición de marzo de 2026 seleccionó como portada, la ilustración de un artículo científico que tiene la autoría de Germán Gomez (INTEQUI-CONICET) y Federico Aballay de la Facultad de Química, Bioquímica y Farmacia (FQBF- UNSL).
El título del trabajo es "Análisis supramolecular y propiedades antimicrobianas de tres polímeros de coordinación basados en bismuto: estructuras cristalinas y superficies de Hirshfeld", investigación que estuvo a cargo de María F. Castro, Martín Fernández Baldo, y Liliana Villegas del Instituto de Química San Luis (INQUISAL-CONICET), Federico Aballay y Cristina Almandoz de la Facultad de Química, Bioquímica y Farmacia (FQBF -UNSL), Mattia Lopresti de la University de Piemonte, Italia; y Germán Gomez del Instituto de Investigaciones en Tecnología Química (INTEQUI-CONICET).

Equipo de investigación: (arriba: izq-derecha) Federico Aballay, María F. Castro, Mattia Lopresti, Cristina Almandóz - (Abajo: izq.-derecha) Martín Fernández Baldo, Liliana Villegas, Germán E. Gomez.
La revista EurJIC (European Journal of Inorganic Chemistry) es una publicación de Chemistry Europe (anteriormente ChemPubSoc Europe), asociación formada por dieciséis (16) sociedades químicas de quince (15) países europeos, que agrupa a más de setenta y cinco mil (75 000) profesionales de la química. Fundada en 1995 por iniciativa de la Sociedad Química Alemana, esta organización se dedica a la evaluación, publicación y difusión de investigaciones científicas de excelencia a través de una familia de revistas académicas de química.
Sobre la imagen seleccionada para formar parte de la tapa de la prestigiosa revista EurJIC, el doctor Germán Gomez explica que lo que se muestra es una alegoría del trabajo científico publicado: "En el centro tenemos los compuestos antimicrobianos y alrededor los microorganismos que se ven afectados por la presencia de estos materiales, mostrando así la actividad antimicrobiana de los MOFs ( destructuras metalorgánicas) de bismuto". Esta producción visual es otra demostración del diálogo que tiene la ciencia y el arte para reflejar de manera sintética un valioso y profundo trabajo de investigación.

Foto de portada seleccionada: Volume 29, Issue9. Revista EurJIC, Chemistry Europe. Autoría: Federico Aballay y Germán Gomez (FQBF-INTEQUI-CONICET-UNSL)
El trabajo publicado se centra en las infecciones causadas por bacterias y hongos que "siguen siendo un desafío para la salud" - comenta el doctor Gomez. El grupo de científicos estudió tres nuevos materiales a base de bismuto, un metal con posible acción antimicrobiana. Primero, estos materiales fueron preparados y analizados para conocer bien su estructura y sus propiedades. Después, se evaluó en el laboratorio si podían frenar el crecimiento de distintos microorganismos, entre ellos bacterias y hongos del género Candida. " Los resultados mostraron que estos compuestos tienen capacidad para inhibir el crecimiento microbiano, lo que los convierte en candidatos interesantes para el desarrollo de nuevos materiales con aplicaciones en salud"- concluye el investigador del INTEQU-CONICET Germán Gómez.
Resumen científico
Las enfermedades causadas por microorganismos, como bacterias, virus y hongos, siguen siendo un problema importante para la salud humana. En este trabajo se sintetizaron y caracterizaron tres polímeros de coordinación basados en bismuto, construidos con ligandos policarboxilato, con posible actividad antibacteriana y antifúngica.
Los compuestos fueron estudiados mediante distintas técnicas de caracterización en estado sólido para conocer sus propiedades estructurales antes de evaluar su actividad biológica. Además, se analizaron sus interacciones intermoleculares y su organización supramolecular. Luego, se ensayó su capacidad inhibitoria in vitro frente a bacterias como Staphylococcus aureus y Bacillus atrophaeus, y frente a especies del género Candida. También se determinó la concentración mínima inhibitoria y se siguió el crecimiento microbiano durante 24 horas en dos especies seleccionadas.
En conjunto, los resultados muestran que estos polímeros de coordinación de bismuto tienen potencial como agentes antimicrobianos prometedores para aplicaciones en salud humana.